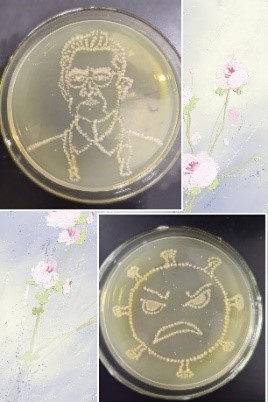
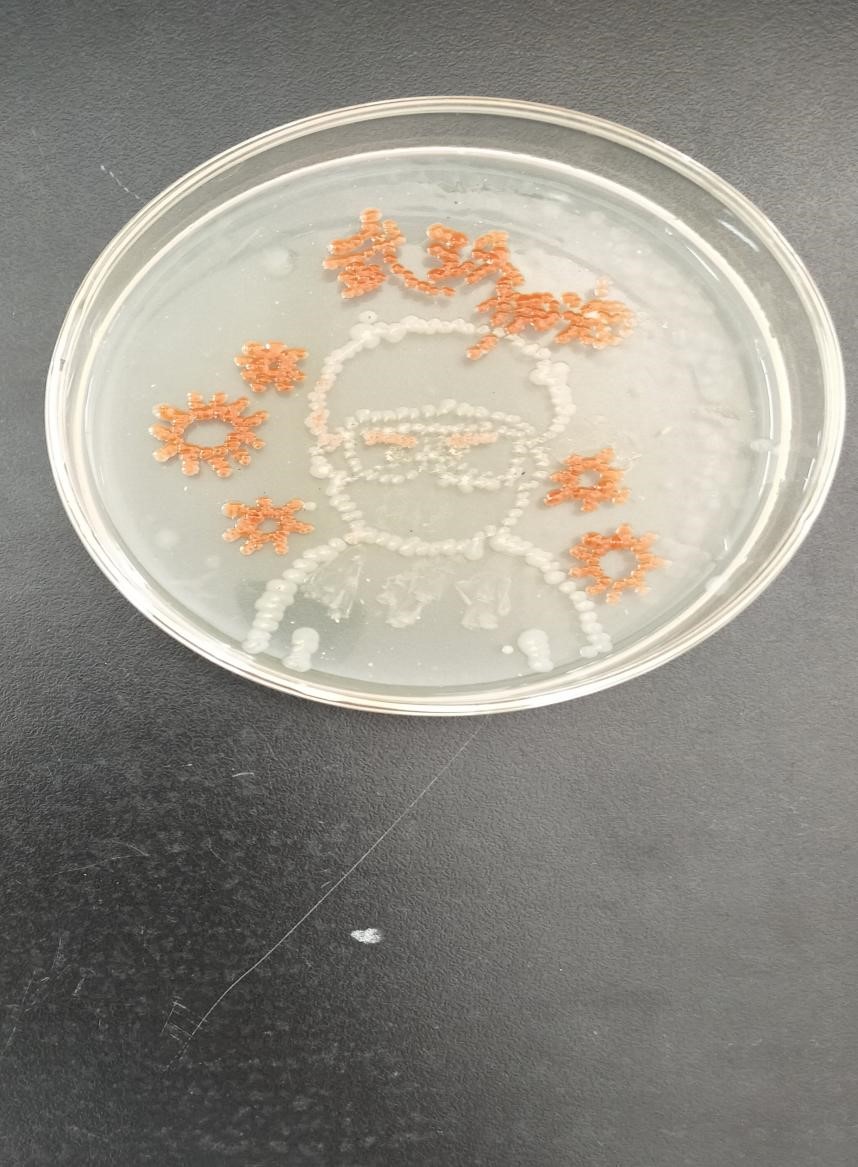

供稿:党委宣传部 审核:王春玲 日期:2021-06-18
近日,由吉林省科学技术协会主办,吉林省科技馆、吉林大学、吉林省生物化学与分子生物学会、吉林大学生物国家级实验教学示范中心、吉林大学化学·生命科学专业国家级实验教学示范中心联合承办的第二届吉林省大学生微生物培养皿艺术大赛落下帷幕,制药工程学院师生在本届大赛中再创佳绩,学生创作的参赛作品中获奖13项,其中一等奖3项,二等奖2项,三等奖8项,指导教师分获各等级指导教师奖,获奖层次和数量均超过往届,实现了我学院在该项赛事中的新突破。
本届大赛于2021年3月31日启动,4月15日截止投稿。自接到大赛通知以来,制药工程学院院长高度重视和大力支持,积极宣传并鼓励师生参赛。此次大赛以“使命”为主题,各团队的学生倾注对微生物研究的专注与热情,用艺术创作后的微生物作品来表达中国人民在党的领导下,抗击新冠疫情的使命担当和创造脱贫攻坚的历史奇迹,以科学与艺术相结合、饱含创意与敬意的创新作品,向中国共产党建党100周年献礼。
据悉,大学生微生物培养皿艺术大赛旨在更好地培养学生创新思维及创造力、提升团队协作和动手实验能力、挖掘学生利用科学知识及创新意识去发现问题及解决问题的潜能。制药工程学院学生通过参加此次比赛,进一步提高了实验操作技能和科学素养,在比拼微生物学知识的同时,培养了学生的创新意识。此次大赛获奖情况亦充分体现了我院课程育人的教学成果。



获奖作品展示

抗疫英姿

传承使命-如意纹

负重前行者——驱魔者、龙城飞将
践行使命,阻击新冠

听党指挥,万众一心

军人之志,民族之魂

拒绝海洋垃圾,守护海洋动物

林深时见鹿

?春逆?,不负使命

雾尽风暖,命运与共

大好河山、寸步不让
最美逆行者

奇迹再现